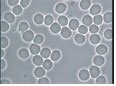

遠赤外線サウナ療法
このサウナには、SGE鉱石を使用していますが、この鉱石は4〜14ミクロンの波長の遠赤外線を大量に放出しており、またマイナスイオンも、トルマリン鉱石の約10倍の放出が認められています。
遠赤外線サウナ療法では、血流の流動性改善、体内毒素・老廃物の排出が科学的に認められています。
■アトピー皮膚炎 サウナ治療併用3ヶ月の変化
 |
→
|
 |
■ミネラルウォーターを飲んでサウナ治療後の赤血球の変化
 |
→
|
|
ドロドロの血液状態が改善されています。
アトピー性皮膚炎のほか、難治性皮膚疾患、リウマチ、膠原病、高血圧、糖尿病、慢性疼痛などの治療に使用しています。